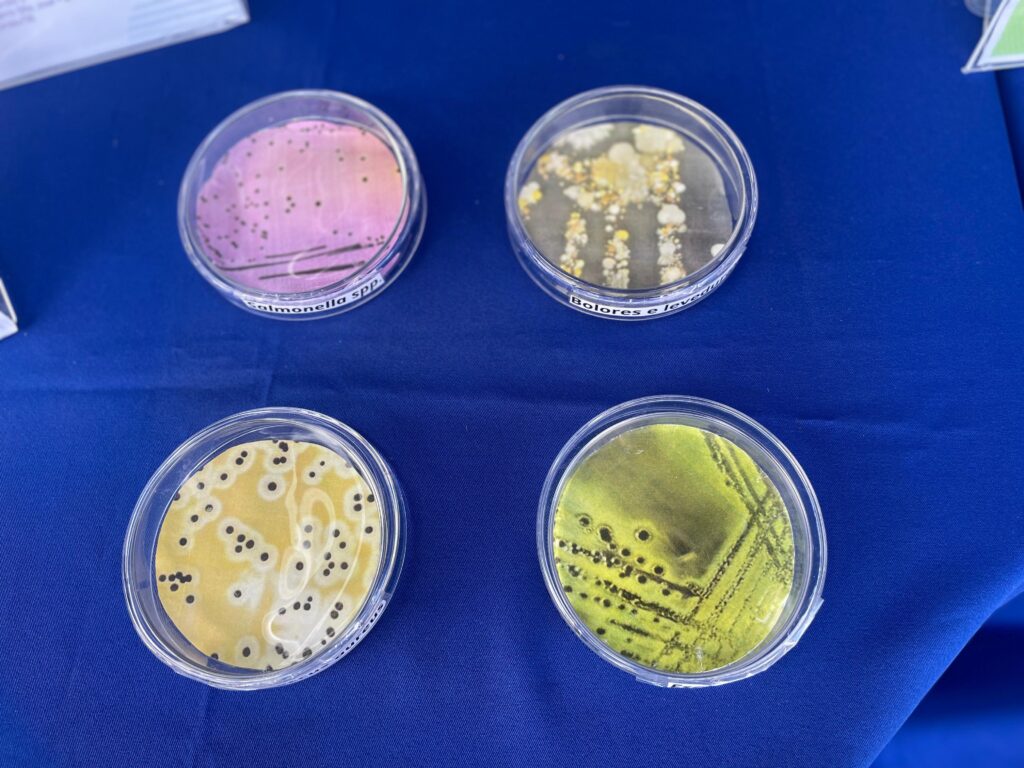

População de Neópolis conheceu ações desenvolvidas pela pasta e suas vinculadas, com destaque para informações científicas e econômicas
Nesta quinta-feira, 23, o governo itinerante ‘Sergipe é aqui’ realizou sua primeira edição de 2025 no município de Neópolis, no baixo São Francisco. Esta é a 38ª cidade a receber o programa, que já acumulou mais de 170 mil atendimentos em todas as regiões do estado. Entre os órgãos da administração estadual a compor a caravana, destacam-se a Secretaria de Estado do Desenvolvimento Econômico e da Ciência e Tecnologia (Sedetec) e suas vinculadas, que vêm ofertando serviços e informações de apoio à pesquisa, ao empreendedorismo e à produção agrícola para os sergipanos.
Das políticas conduzidas pelo Governo de Sergipe via Sedetec, a transição energética figura entre as mais importantes. E com o ‘Sergipe é aqui’, a população pode se tornar mais próxima do tema, conhecendo de perto o que tem sido feito pelo Estado para estimular uma gestão mais sustentável e responsável da energia. Em Neópolis, a pesquisadora Amanda de Azevedo Gonçalves, que atua no Sergipe Parque Tecnológico (SergipeTec), foi uma das porta-vozes dessa transformação.
“Trouxemos a pesquisa em hidrogênio verde do SergipeTec e da Sedetec, cujo objetivo é desenvolver maquetes que mostram a produção de energia renovável por meio de fontes eólicas e fotovoltaicas. Essa energia alimenta outro sistema de produção de hidrogênio por eletrólise da água, que além de ser uma alternativa de combustível renovável e limpo, é também uma fonte energética. Esse gás de hidrogênio pode ser usado em processos industriais, como a produção de manteiga, margarina, e cimento, e também como combustível, como é o caso de carros movidos à célula de hidrogênio”, resumiu a pesquisadora.
Do outro lado da bancada onde Amanda descreveu e expôs processos químicos, a população de Neópolis acompanhou a apresentação. Foi o caso da professora Judite Ramos dos Santos, da Escola Estadual José Moreno de Santana, que chegou ao estande da Sedetec ao lado de um de seus alunos. “Estamos conhecendo os projetos e as novidades. É ótimo para a comunidade, para as pessoas terem mais conhecimentos e darem mais valor às coisas. Para os alunos vai ser muito importante, um incentivo a outras experiências e para o mercado de trabalho”, prenunciou.
Outros serviços
Além do SergipeTec, o Instituto Tecnológico e de Pesquisas do Estado de Sergipe (ITPS) também levou informes científicos ao ‘Sergipe é aqui’, divulgando ações desenvolvidas pelo Laboratório de Microbiologia, entre outras iniciativas. O ITPS disponibilizou, ainda, análises de solo e água para irrigação, levando suporte aos agricultores de Neópolis e seu entorno.
Também presente, a Companhia de Desenvolvimento Econômico de Sergipe (Codise) distribuiu material informativo a respeito das potencialidades industriais do estado, estimulando a atração de investimentos. Com sua equipe de plantão, a Codise direcionou os visitantes a conhecer os incentivos do Programa Sergipano de Desenvolvimento Industrial (PSDI), considerado um dos mais atrativos do país para empresas em implantação e/ou expansão.